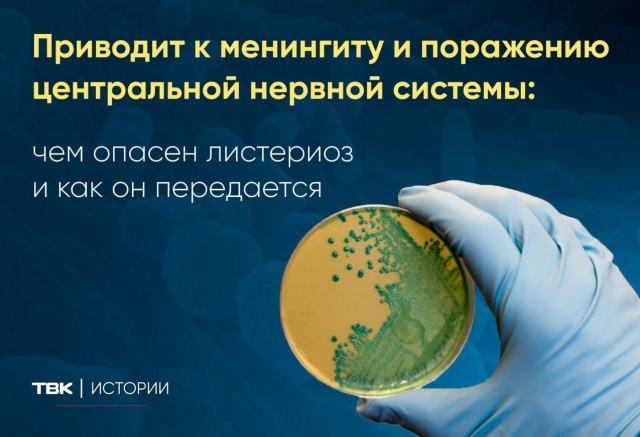
Чем опасен листериоз и как он передается?

Чем опасен листериоз и как он передается?
1745
12 августа 2023
Листериоз – это острое инфекционное заболевание, которое способно привести к серьезным осложнениям. Насколько оно опасно и как можно им заразиться? Собрали ответы врача-инфекциониста Федерального Сибирского научно-клинического центра ФМБА России Елены Беховой в карточках ТВК.
Последние новости
- 09:29 Банкротство бизнеса: эксперт о правилах, рисках и долгах, которые нельзя списать
- 14.06 «Вопросы ЖКХ»: как не платить за вывоз мусора на даче в зимний период?
- 14.06 Дожди, солнце и до +27°C: прогноз погоды на неделю в Красноярске
- 11.06 Новости ТВК 11 июня 2026 года
- 11.06 Вандалы повредили бронзового суслика Афоню в сквере «Юдинский»